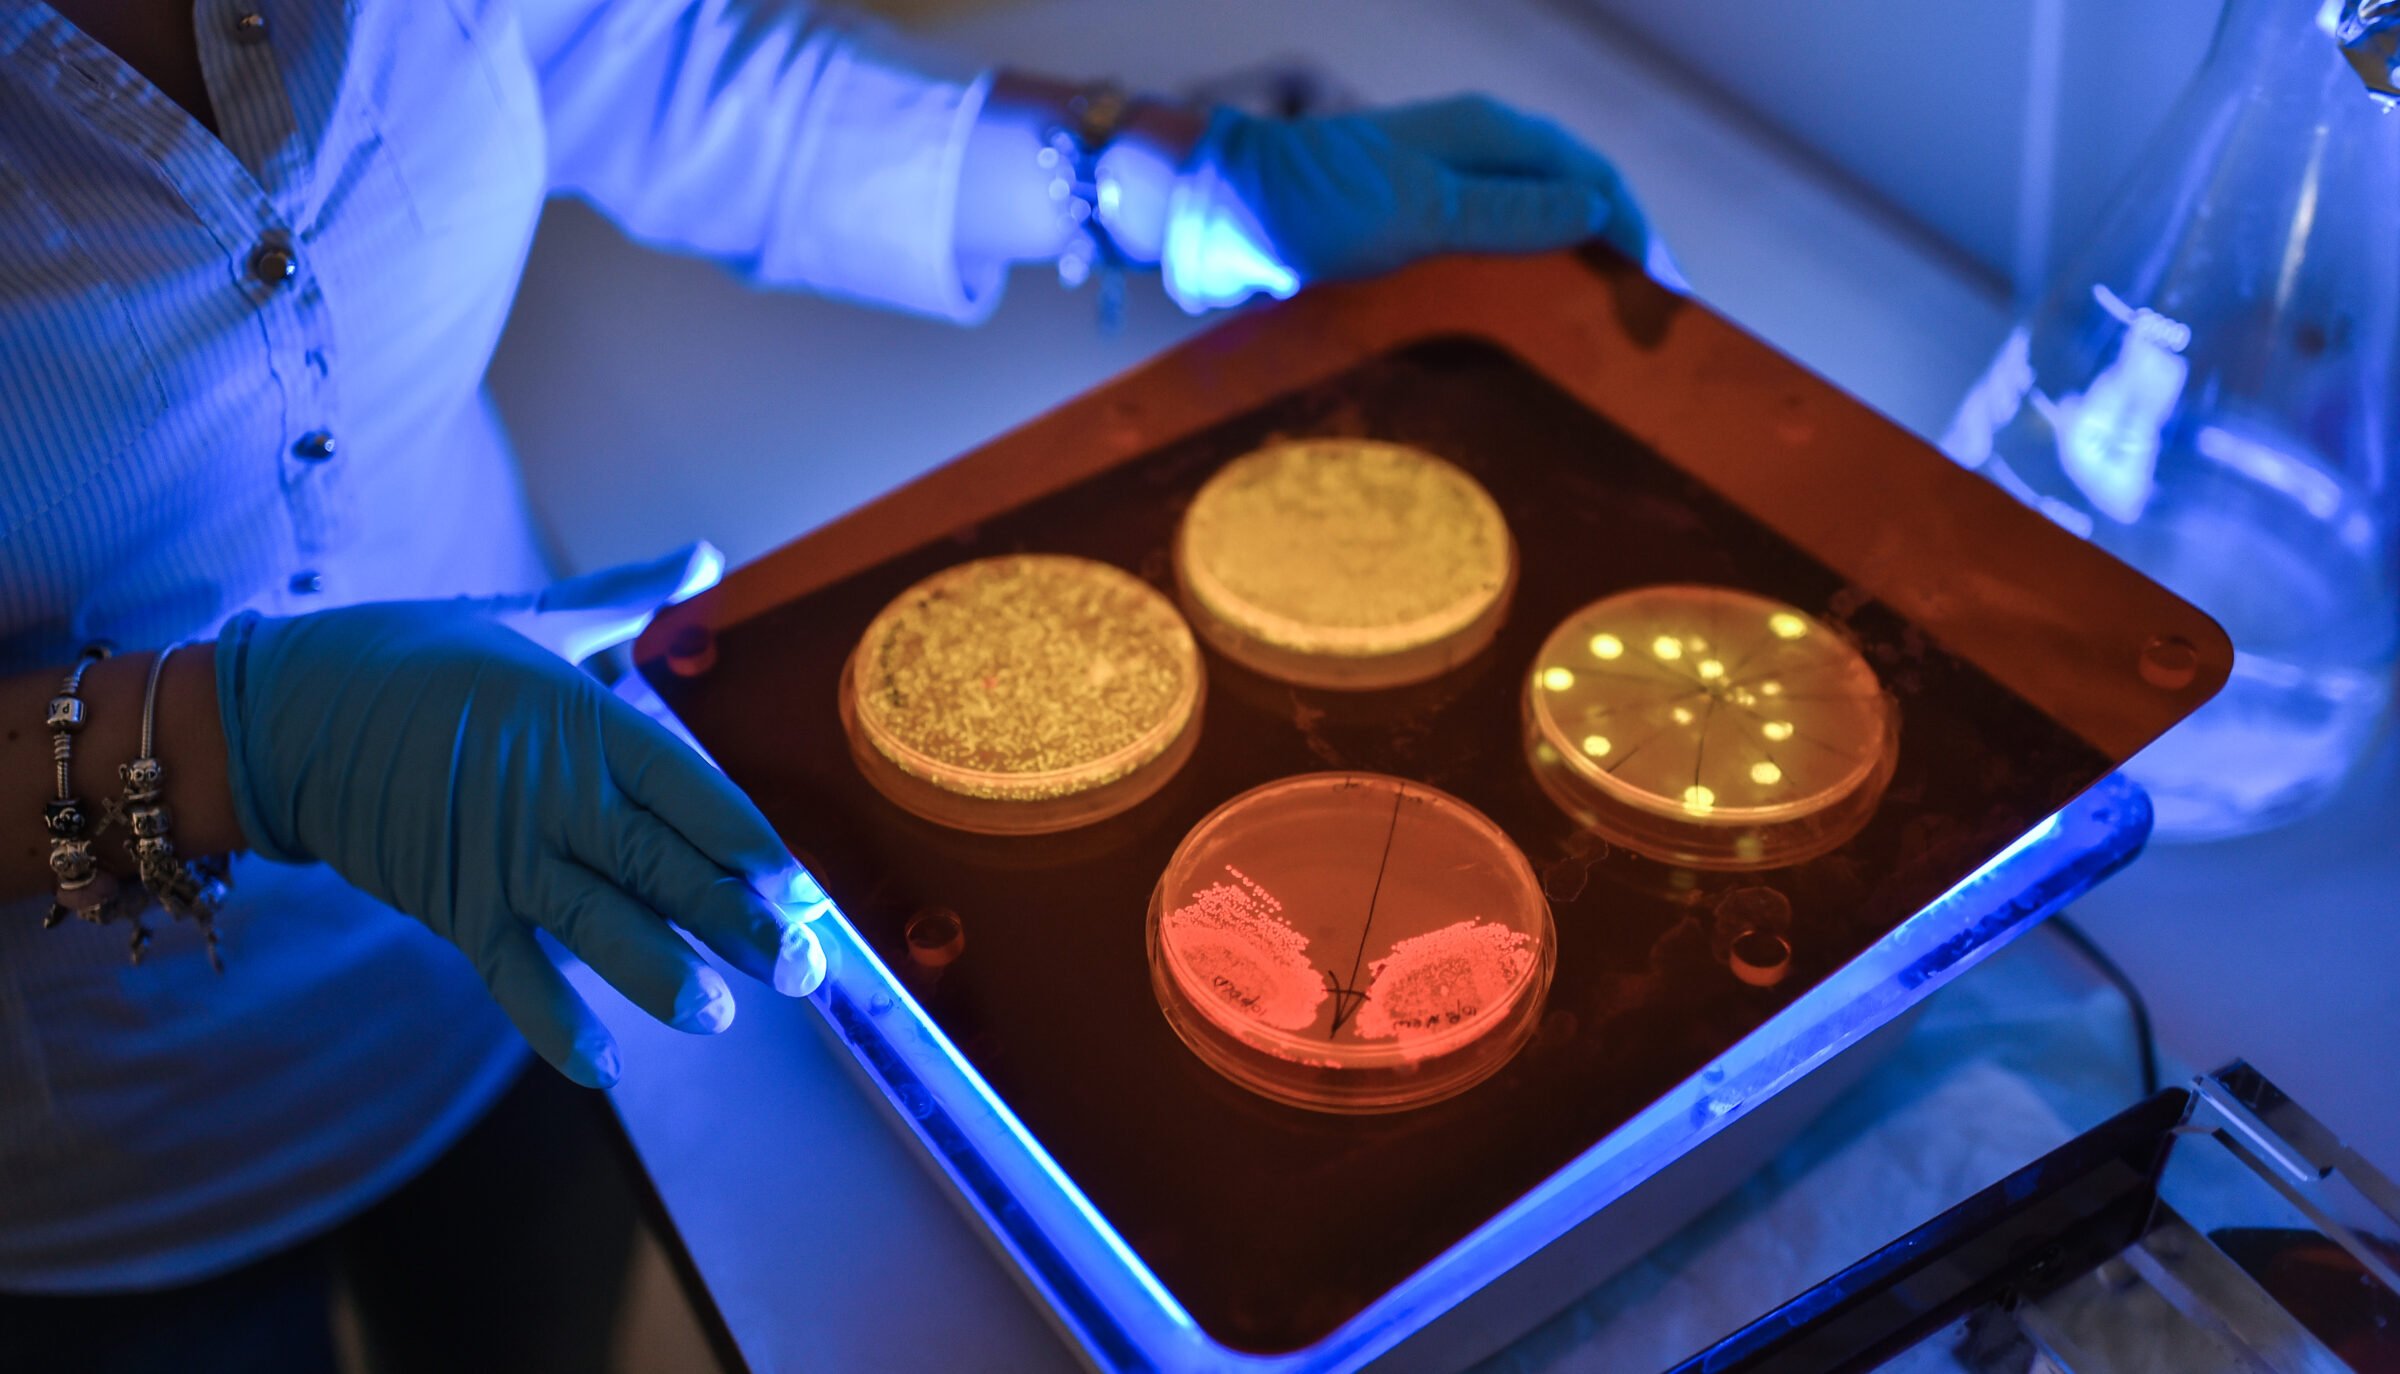

TECHNION CANADA

-

About the Client
Technion Canada supports the growth and success of the Technion – Israel Institute of Technology, a global innovation powerhouse. Their investments in the Technion’s research, education, and innovation efforts advance critical breakthroughs that benefit the State of Israel and the global good.
-

What We Did
We developed a donor-centric content strategy designed specifically for Canadian audiences, focusing on causes and achievements that resonate deeply, such as healthcare innovation, sustainability, and global technological leadership.
To grow Technion Canada's digital footprint, we launched a LinkedIn page targeted toward professional audiences, complementing their existing Facebook presence. Content was tailored to highlight alumni success stories, cutting-edge Technion research, and community-building efforts.We also prioritized alumni engagement, tapping into this highly valuable network to grow visibility and expand the support base. By maintaining consistent messaging across LinkedIn and Facebook, we broadened Technion Canada’s reach while creating a cohesive, mission-driven digital presence.
Targeted campaigns, event promotions, and curated storytelling further supported donor engagement and amplified fundraising efforts. -

The Goal
Technion Canada aimed to strengthen its social media presence to better support fundraising efforts, engage its Canadian donor and alumni base, and amplify the Technion’s global impact stories.
The goal was to position Technion Canada as an essential link between Canadian supporters and one of the world’s leading institutions for innovation and discovery.
RESULTS
-

278.57% audience growth
across platforms since 2022
-

Over 2.2M impressions
across platforms since 2022
-

Over 125K engagements
across platforms since 2022
-

Successfully launched LinkedIn page
driving engagement with professional audiences
-

Over 61K link clicks
across platforms since 2022
-

Platforms managed
Facebook, LinkedIn
-

Leveraged Facebook advertising
and event promotion tools to boost attendance at events and enhance fundraising efforts